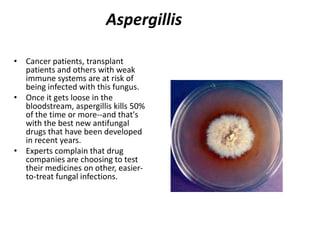
AspergillisCancer patients, transplant patients and others with weak immune systems are at risk of being infected with this fungus. Once it gets loose in the bloodstream, aspergillis kills 50% of the time or more--and that's with the best new antifungal drugs that have been developed in recent years. Experts complain that drug companies are choosing to test their medicines on other, easier-to-treat fungal infections.

This document discusses antibiotic resistance and how it arises through natural selection. It provides background on the discovery and early use of antibiotics like DDT and penicillin. However, as bacteria evolved resistance, new antibiotics had to be continually developed to keep ahead of evolving resistance. The overuse and misuse of antibiotics, especially in agriculture, has accelerated this process and reduced the effectiveness of many existing drugs. New approaches are needed that apply principles of evolutionary biology to slow further development of resistance.